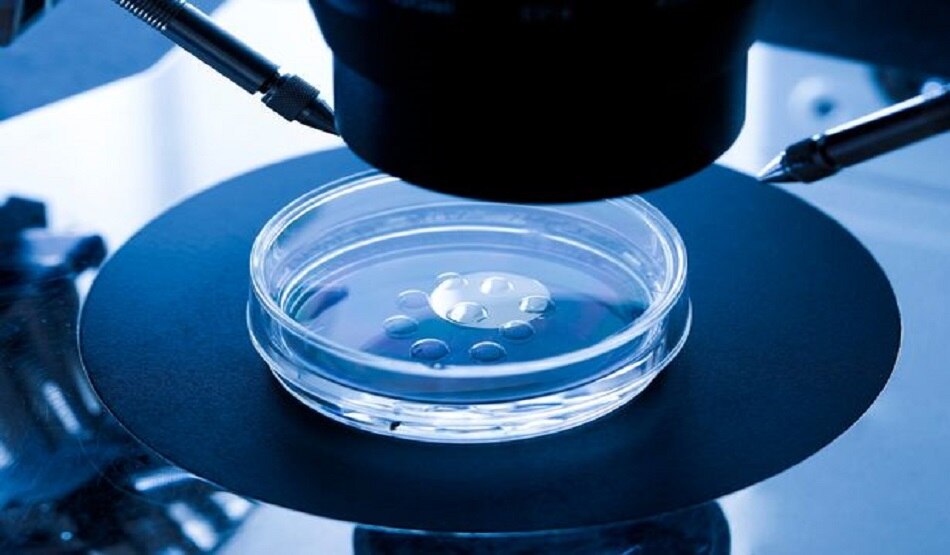
Woman

जिस डॉक्टर से 9 साल से इलाज करा रही थी महिला, उसी के स्पर्म से हुआ था जन्म, केस दर्ज
अमेरिका में एक महिला उस वक्त हैरान रह गई जब उसे पता चला की जिस स्त्री रोग विशेषज्ञ पुरुष डॉक्टर से वो बीते 9 साल से अपना इलाज करा रही है वो उसके जैविक पिता है. इसका बाद महिला ने उस डॉक्टर के खिलाफ मुकदमा दर्ज करा दिया. (तस्वीर - स्क्रीन ग्रैब)
35 साल की मॉर्गन हेलक्विस्ट ने डॉक्टर पर गंभीर आरोप लगाते हुए मुकदमा दायर किया है जिसमें दावा किया है कि 70 वर्षीय स्त्री रोग विशेषज्ञ मॉरिस वोर्टमैन उनके पिता हैं. (सांकेतिक तस्वीर/स्क्रीन ग्रैब)
मिरर की रिपोर्ट के मुताबिक महिला ने बताया कि उसका जन्म कृत्रिम गर्भाधान (टेस्ट ट्यूब) के माध्यम से हुआ था और डॉक्टर वोर्टमैन वही शख्स थे जिन्होंने उसकी मां को बच्चा पैदा करने के लिए स्पर्म दिया था. (सांकेतिक तस्वीर/स्क्रीन ग्रैब)
हालांकि रिपोर्ट में कहा गया है कि हेलक्विस्ट के माता-पिता मूल रूप से मानते थे कि स्पर्म एक मेडिकल छात्र का था. (सांकेतिक तस्वीर/स्क्रीन ग्रैब)
अप्रैल महीने में न्यूयॉर्क के रोचेस्टर में मासिक धर्म संबंधी विकार केंद्र में वोर्टमैन की नियुक्ति के बाद महिला को लगने लगा की कहीं उसके असली पिता वही तो नहीं है. (सांकेतिक तस्वीर/स्क्रीन ग्रैब)
वाशिंगटन पोस्ट के अनुसार, मुकदमे में दावा किया गया है कि वोर्टमैन ने अपनी पत्नी को हेलक्विस्ट के अल्ट्रासाउंड को देखने के लिए आमंत्रित किया था. वोर्टमैन ने कथित तौर पर कहा, "आप वास्तव में एक अच्छे बच्चे हैं, बहुत अच्छे बच्चे हैं." बाद के महीनों में, एक डीएनए परीक्षण के बाद पता चला कि वोर्टमैन हेलक्विस्ट के जैविक पिता थे. (सांकेतिक तस्वीर/स्क्रीन ग्रैब)
मुकदमे के अनुसार, सितंबर 1985 में पैदा हुई हेलक्विस्ट इस तथ्य को जानने के बाद "सदमे में थी. उसने कहा कि अगर उसे पहले से पता होता कि जिस डॉक्टर के पास वो जा रही है वो उसके जैविक पिता हैं तो वो उनके पास अपना इलाज के लिए कभी नहीं जाती. (सांकेतिक तस्वीर/स्क्रीन ग्रैब)